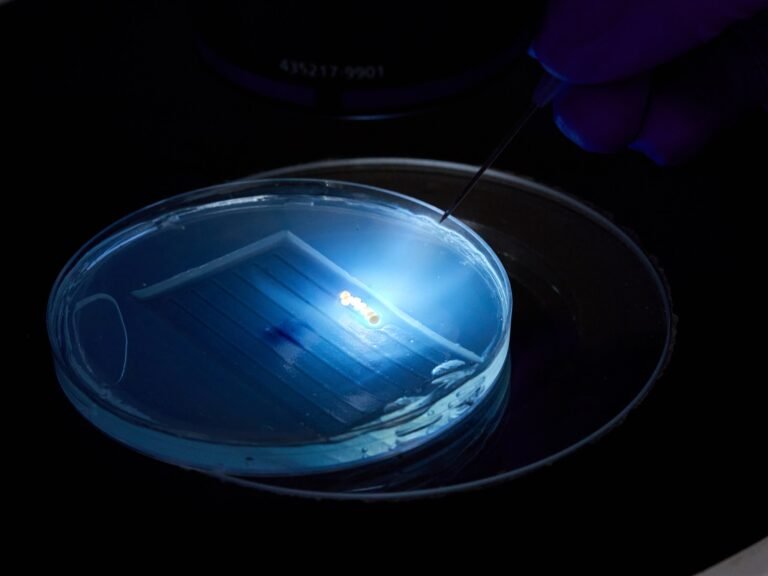

The Center for Aquaculture Technologies (CAT), a leading provider of genetics solutions in aquaculture, has announced a collaboration with C4U Corporation. Their joint effort aims to apply CRISPR-Cas3 technology to promote genome editing in major commercial fish species and drive technological advancements within the industry.
CRISPR-Cas3 technology was developed from the research work of Professor Tomoji Mashimo, currently at the Institute of Medical Science, University of Tokyo, who is also a co-founder of C4U, along with other contributions. The CRISPR-Cas3 platform provides unique advantages, such as increased safety through a reduction in unintended mutations and the capability for broad gene alterations near the target site. It stands out as an attractive option for genome editing, unencumbered by the intricate patents associated with CRISPR-Cas9, offering a practical substitute.
Akimitsu Hirai, President & CEO of C4U, commented on the ethos behind the formation of C4U, “our commitment through C4U—CRISPR for you—is to democratize this advanced technology, ensuring it is accessible for improving health outcomes and sustainable food production. The name C4U encapsulates our vision of bringing the benefits of CRISPR technology directly to the industries that need it most, from medical therapies to enhancing aquaculture’s growth, aligning with CAT’s mission to meet the global food demand responsibly.”
The Center for Aquaculture Technologies is committed to delivering technologies that are not only innovative but also accessible to the aquaculture industry. This research initiative with C4U represents a stride towards fulfilling that commitment. At CAT, there’s a firm belief that genome editing (GE) presents the most feasible and sustainable pathway to meet the world’s increasing food requirements and contribute to the economic vitality of the aquaculture sector.
John Buchanan, CEO of CAT, underscores this approach: “Our collaboration with C4U is a key part of our mission to introduce advanced genome editing technologies to aquaculture. We are invested in pursuing relationships that propel the industry forward, addressing the global food demand sustainably and responsibly.”